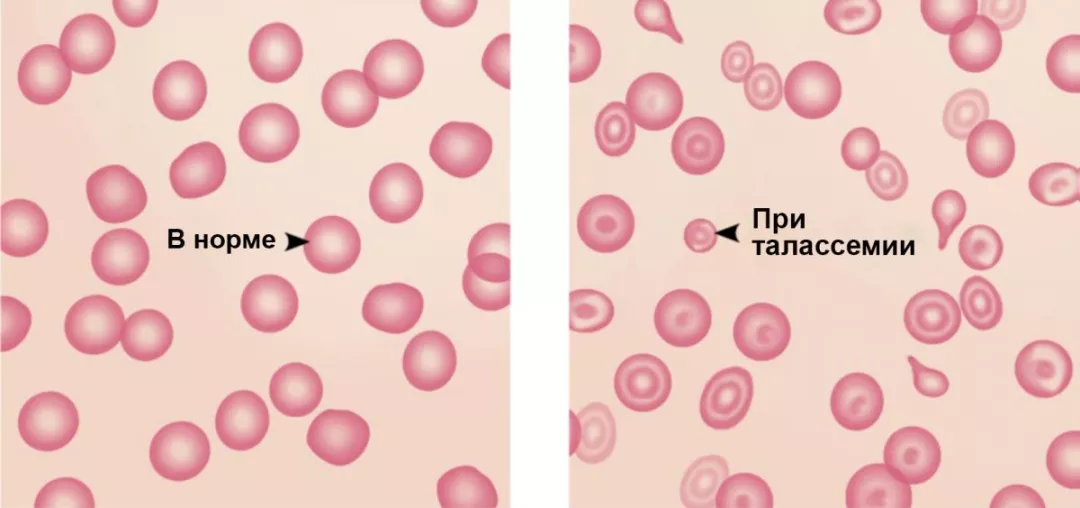
Рисунок 3. Эритроциты в норме и при талассемии

Талассемия
Талассемия представляет собой разнородное семейство генетических заболеваний, при которых наблюдается частичная или полная супрессия образования нормального гемоглобина (Hb). Клиническая тяжесть различных видов талассемии варьирует от бессимптомного течения до тяжелого заболевания с потребностью в трансфузиях (это зависит от степени поражения синтеза гемоглобина)1,2.
Наиболее значимые аспекты: Гемоглобин (Hb)
Гемоглобин (компонент эритроцитов) представляет собой белок, ответственный за транспорт кислорода. Гемоглобин состоит из четырех полипептидных цепей, называемых глобином, каждая из которых связана с одним циклическим небелковым компонентом под названием гем. В центре каждой молекулы гема содержится ион железа (Fe2+), который способен обратимо связывать одну молекулу кислорода, то есть всего 4 молекулы кислорода на 1 белок Hb3.
В норме Hb содержит 2 α и 2 не-α (например, β,γ или δ) глобиновые цепи. Комбинации этих цепей образуют различные виды гемоглобина, которые характерны для эмбрионов, плодов и взрослых людей (см.Рисунок 2). Основным гемоглобином взрослых людей является гемоглобин А (HbА), включающий 2 α и 2 β цепи1.
Талассемии возникают в результате дефектов образования α- или β-глобиновых цепей: α-талассемии возникают в результате дефекта синтеза α-цепей, в то время как β-талассемии возникают в результате дефекта синтеза β-цепей. Клинические проявлений талассемий обусловлены отсутствием функционирующего HbА и избыточного накопления глобиновой цепи, синтез которой не нарушен (β-глобина при α-талассемии и α-глобина при β-талассемии)1.
Эпидемиология
Талассемии встречаются преимущественно в Юго-Восточной и Южной Азии, странах Средиземноморья, на Среднем Востоке, в Северной и Центральной Африке. Географическое распределение α- и β-талассемий изображено на Рисунке 12,4,5
Распространенность талассемии и других патологий Hb в этих регионах, по-видимому, коррелирует с распространенностью малярии. Тем не менее, в результате миграции эти заболевания также распространились в Северную и Южную Америку, Европу и Австралию.

Рисунок 1. Распространение талассемии в мире5
Этиология и патогенез
Талассемии вызываются мутациями, влияющими на определенные этапы экспрессии глобинового гена. Известно примерно 200 мутаций, способных вызвать талассемию. Тем не менее, у подавляющего большинства пациентов идентифицируется примерно 15 мутаций2.
Талассемии наследуются как патологические аллели одного или нескольких глобиновых генов, расположенных на Хромосомах 11 и 16 (Рисунок 2). Эти изменения варьируют от полной делеции до реаранжировки локусов и точечных мутаций, нарушающих транскрипцию, процессинг или трансляцию генетической информации глобинов2.

Рисунок 2. Глобиновые гены и их дисфункция при β-талассемии7
Как уже упоминалось ранее, талассемия возникает в том случае, когда генетическая мутация приводит к уменьшению или прекращению образования α- и β-глобиновых цепей. Результатом образования дефектных глобиновых цепей является уменьшение синтеза функционирующих тетрамеров Hb. Это образование патологического Hb влияет на состав и внешний вид эритроцитов; они становятся гипохромными и микроцитарными (см. Рисунок 3)2.
Рисунок 3. Эритроциты в норме и при талассемии
Гипохромный
Состояние снижения гемоглобина в эритроцитах6.
Микроцитарный
Состояние, когда эритроциты являются патологически мелкими6.
Гемолитическая анемия
Анемия, обусловленная разрушением эритроцитов6.
Гемолиз
Разрушение эритроцитов6.
Кроме того, синтез непораженной глобиновой цепи продолжается с нормальной скоростью, что ведет к ее несбалансированному накоплению. Избыточные нормальные глобиновые цепи образуют агрегаты, оказывающие токсическое действие на эритроциты, вследствие чего поврежденные эритроциты досрочно разрушаются в костном мозге. Таким образом, процесс эритропоэза является неэффективным, и наступает гемолитическая анемия (Рисунок 4)1,2,8.

Рисунок 4. Патогенез β-талассемии5
Основные типы талассемий
Две основные категории (α- и β-талассемии) можно далее подразделить на несколько различных подтипов в зависимости от ряда генетических и иных факторов (Таблица 1)8.
| α-Талассемии, вызванные дефектом синтеза α-глобиновой цепи | |||
|---|---|---|---|
| Малая α‑талассемия-2 | Малая α‑талассемия-1 | HbН α‑талассемия или болезнь HbН | Водянка плода |
| Вызвана делецией 1 из 4 локусов α‑глобина9 | Вызвана делецией 2 из 4 локусов α‑глобина1,9 | Вызвана делецией 3 из 4 локусов α‑глобина9 | Вызвана делецией всех 4 локусов α‑глобина9 |
| β-Талассемии, вызванные дефектом синтеза β-глобиновой цепи | |||
| Малая β‑талассемия или малая талассемия | Промежуточная β‑талассемия | Гемоглобин Е (HbЕ) / β‑талассемия | Большая β‑талассемия |
| Вызвана нарушением 1 гена β‑глобина9 | Вызвана тяжелым нарушением 1 гена или легкими нарушениями 2 генов β‑глобина. Обычно характеризуется меньшей тяжестью по сравнению с большой β‑талассемией10 | Вызвана нарушением генов, приводящим к образованию патологического типа Hb под названием HbЕ11 | Вызвана наследованием тяжелых нарушений 2 β‑глобиновых генов9 |
Таблица 1. Подтипы α- и β-талассемий1,9
Клиническая симптоматика
Основным клиническим проявлением талассемий является анемия. Тем не менее, исходя из степени дисбаланса глобиновых цепей, клиническая тяжесть и потребность в гемотрансфузиях на фоне талассемий может значительно варьировать (Рисунок 5)1,4.
- На одном конце диапазона клинических проявлений находятся легкие формы талассемий, например, малая β-талассемия, которая в типичных случаях протекает бессимптомно с легкой анемией или без нее, вследствие чего потребность в гемотрансфузиях отсутствует9.
- В середине диапазона находятся виды талассемий, при которых не требуются или лишь эпизодически требуются гемотрансфузии. Эта группа талассемий определяется как трансфузионно-независимые талассемии (NTDT)12. На другом конце данного диапазона располагаются тяжелые формы талассемий, например, β-талассемия, при которых требуются регулярные гемотрансфузии. Эти талассемии определяются как трансфузионно-зависимые талассемии (TDT)13.

Рисунок 5. Диапазон клинических проявлений талассемии5,14
α-Талассемия
Малая α-талассемия-2
Малая α-талассемия-2 представляет собой состояние бессимптомного носительства без анемии9.
Малая α-талассемия-1
Малая α-талассемия-1 не сопровождается патологическими физикальными симптомами, при этом анемия отсутствует или является минимальной1,9.
HbН α-талассемия / Болезнь HbН
При HbН α-талассемии, также называемой болезнью гемоглобина Н (HbН), образуется лишь 25%-30% от нормального количества HbА. HbН представляет собой агрегаты β-гемоглобиновых цепей, которые оседают в циркулирующих эритроцитах. У пациентов с болезнью HbН наблюдается среднетяжелая анемия и менее выраженный неэффективный эритропоэз. Клиническая картина напоминает промежуточную β-талассемию, и пациенты обычно доживают до взрослого возраста без потребности в гемотрансфузиях9,15.
Водянка плода
Водянка плода является наиболее тяжелой формой α-талассемии. Она сопровождается образованием одной из форм гемоглобина (гемоглобин Барта), который не способен доставлять кислород в ткани. Водянка плода в большинстве случаев приводит к гибели плода.
β-Талассемия
Малая β-талассемия / Малая талассемия
Малая β-талассемия (также называемая малая талассемия) обычно протекает бессимптомно с легкой анемией или без анемии9. В костном мозге может наблюдаться легкая эритроцитарная гиперплазия5.
Гиперплазия
Избыточная пролиферация нормальных клеток6.
Эритропоэтин
Продуцируемый почками цитокин, который стимулирует пролиферацию эритроцитов6.
Экстрамедулярный
Расположенный за пределами мозгового вещества или костного мозга6.
Промежуточная β-талассемия
Промежуточная β-талассемия обычно протекает менее тяжело по сравнению с большой β-талассемией. У этих пациентов наблюдается более легкая форма данного заболевания, и они часто способны жить без гемотрансфузий. У многих пациентов наблюдается уровень Hb 6-9 г/дл, они относительно хорошо растут и развиваются, и доживают до взрослого возраста. В случае возникновения осложнений могут потребоваться гемотрансфузии. У некоторых пациентов уровень Hb колеблется в диапазоне 5-6 г/дл. У многих из таких больных наблюдаются нарушения развития, при этом возможны деформации скелета. Для предотвращения этих осложнений рекомендуются гемотрансфузии10.
Гемоглобин Е (HbЕ) / β-Талассемия
Клинические проявления HbЕ / β-талассемии схожи с другими формами промежуточной β-талассемии. У пациентов с β-талассемией / болезнью HbЕ клинические проявления характеризуются значительной вариабельностью – от легких симптомов с нормальным ростом и развитием без потребности в гемотрансфузиях до тяжелых форм с выраженной анемией, нарушениями роста, тяжелыми костными изменениями, спленомегалией и тяжелой перегрузкой железом. У пациентов с тяжелыми формами заболевания поражаются практически все органы и ткани, при этом клинические симптомы могут быть столь же серьезными, что и у пациентов с трансфузионно-зависимой большой талассемией11.
Большая β-Талассемия
Большая β-талассемия проявляется в течение первых 6-9 месяцев. У этих пациентов наблюдается тяжелая анемия, и им необходимы множественные гемотрансфузии. Отсутствие лечения может приводить к нарушению роста, дисфункции многих органов и даже преждевременной смерти9.
Помимо анемии при β-талассемии могут присутствовать и другие симптомы. Они преимущественно касаются костного мозга и селезенки. Без гемотрансфузий анемия ведет к гипоксии, стимулирующей образование эритропоэтина. Это в свою стимулирует экспансию гемопоэтических тканей костного мозга. В результате этого у детей с β-талассемией без гемотрансфузий основным клиническим симптомом является нарушение роста и развития. Как это видно из Рисунка 6 происходит эрозия костей лица и черепа с образованием новой костной ткани, что служит причиной для патологических изменений внешнего вида5. Другим следствием неэффективного образования эритроцитов в костном мозге является экстрамедулярный эритропоэз, при котором клетки крови образуются в селезенке, печени и иногда в лимфатических узлах. Это приводит к увеличению данных органов (например, гепатоспленомегалии) (Рисунок 6)5.

Рисунок 6. Клинические проявления β-талассемии. На изображении слева продемонстрированы костные выросты на черепе. Вздутие живота у мальчика на правом рисунке обусловлено увеличением селезенки5
Трансфузионно-независимая талассемия (NTDT)
Типы трансфузионно-независимой талассемии
Трансфузионно-независимая талассемия представляет собой гетерогенную группу талассемий с различными фенотипами и генотипами, однако со схожей клинической картиной. В целом, пациентам с данным заболеванием не требуются регулярные гемотрансфузии для их жизни, тем не менее, в эпизодических случаях может возникать потребность в гемотрансфузиях (например, при инфекциях, во время беременности или на более поздних этапах вследствие спленомегалии или других осложнений). Типы талассемий, объединяемых в категорию трансфузионно-независимой талассемии включают9,10,11,16.
- Промежуточная β-Талассемия
- β-Талассемия / Болезнь HbЕ
- α-Талассемия с гемоглобином Н (болезнь HbН)
Генотип
Совокупность унаследованной информации, присутствующей в организме6.
Фенотип
Экспрессия генов, присутствующих в организме; некоторые из них были унаследованы, в то время как на другие могут повлиять факторы внешней среды6.
Патогенез трансфузионно-независимой талассемии
Как и в случае с многими другими формами талассемии у пациентов с трансфузионно-независимой талассемией на очень ранних этапах жизни развивается тяжелая анемия. Помимо анемии трансфузионно-независимая талассемия часто сопровождается рядом клинических симптомов, таких как неэффективный эритропоэз, перегрузка железом и повышенная скорость свертывания крови. Распространенность и тяжесть этих клинических проявлений отличается от соответствующих симптомов у пациентов с β-талассемией, и на их развитие влияет ряд факторов, включая тип унаследованной трансфузионно-независимой талассемии, характеристики самих пациентов и последующую терапию заболевания14,16.
Перегрузка железом у пациентов с трансфузионно-независимой талассемией возникает в результате неконтролируемой абсорбции железа в кишечнике. При трансфузионно-независимой талассемии избыток железа накапливается преимущественно в гепатоцитах, что может способствовать развитию фиброза и цирроза печени, а также потенциально приводить к развитию гепатоцеллюлярной карциномы. Кроме того, у пациентов с трансфузионно-независимой талассемией без лечения может наблюдаться риск развития связанного с железом нарушения функции сердца (даже без признаков отложения железа в сердце). Кроме того, существует риск развития связанных с железом заболеваний эндокринных желез, поражений костной ткани, тромбоза и тромбоэмболии легочной артерии17.
Диагноз
Талассемию можно диагностировать при помощи различных методов, включая18,19.
- Анамнез и обследование
- Общий клинический анализ крови
- Электрофорез гемоглобина и высокоэффективная жидкостная хроматография (ВЭЖХ)
- Различные методы визуализации
- Молекулярный генетический анализ
- Дифференциальная диагностика
Анамнез и обследование
У детей с большой β-талассемией могут наблюдаться следующие клинические проявления18.
- Тяжелая микроцитарная анемия
- Легкая желтуха
- Гепатоспленомегалия
Клинические проявления у пациентов с трансфузионно-независимой талассемией обычно развиваются в более позднем возрасте (2-6 лет) по сравнению с трансфузионно-зависимой талассемией. Клинические симптомы у пациентов с трансфузионно-независимой талассемией и трансфузионно-зависимой талассемией могут быть схожи, однако обычно отличаются более легким течением13,18.
Анизоцитоз
Крайне выраженная изменчивость размера клеток, в частности эритроцитов6.
Общий клинический анализ крови
По результатам общего клинического анализа крови у пациентов с большой β-талассемией обычно наблюдается снижение уровня Hb до значения <7 г/дл. У пациентов с промежуточной β-талассемией уровни Hb обычно колеблются в диапазонеот 7 до 10 г/дл. Морфологические изменения, наблюдаемые в мазке периферической крови, включают микроцитоз, гипохромию с практически полным обесцвечиванием эритроцитов и анизоцитоз. Могут присутствовать эритроциты патологической формы, например, фрагментированные или мишеневидные клетки (с небольшим количеством гемоглобина в центре, что делает их похожим на мишень), а также клетки с зернистостью9,18.
Электрофорез гемоглобина и высокоэффективная жидкостная хроматография
Электрофорез Hb и ВЭЖХ используется для количественного и качественного анализа Hb. Эти методы позволяют определить тип и количество гемоглобина у пациента. Различные виды β-талассемии характеризуются разным паттерном распределения Hb. У пациентов с малой β-талассемией уровень HbА обычно снижен или отсутствует на фоне повышения уровня HbА2 и HbF. Выявление HbН у новорожденных по результатам электрофореза часто указывает на присутствие α-талассемии. С другой стороны, результаты электрофореза Hb у взрослых людей с малой α-талассемией обычно нормальны. Электрофорез Hb и ВЭЖХ также позволяют выявить другие отклонения Hb, способные повлиять на течение β-талассемии20,21.
Визуализация
Важную роль в диагностике, лечении и профилактике токсического действия железа у пациентов с риском перегрузки железом играют процедуры визуализации сердца и печени, позволяющие оценить уровень железа.20,21.
Наиболее значимые аспекты: Т2*-взвешенная магнитно-резонансная томография
Для непрямого измерения уровня железа в сердце и печени можно использовать магнитно-резонансную томографию (МРТ). На изображениях МРТ визуализируются протоны воды (положительно-заряженные частицы), поскольку они диффундируют около отложений железа в тканях. Диффундирующие протоны могут приводить к затемнению изображения МРТ в степени, которая пропорциональна количеству железа в тканях. Эта степень определяется как Т2* и измеряется в миллисекундах (мс). Т2* становится короче, то есть изображения темнеют быстрее по мере повышения концентрации железа19,22.
Молекулярный генетический анализ
Диагноз талассемии также можно поставить при помощи молекулярных генетических анализов. Они позволяют выявить распространенные мутации глобиновых генов, которые приводят к развитию различных форм талассемий. Генетическое консультирование и пренатальная диагностика также используется у отдельных лиц и у пар из группы риска18.
Дифференциальный диагноз
Поскольку микроцитарная анемия может быть обусловлена и рядом других причин, например, дефицитом железа, отравлением свинцом и видами анемии помимо талассемии, может потребоваться дальнейший анализ крови. Ряд дополнительных тестов могут включать оценку среднего объема эритроцитов (MCV) и ширину распределения эритроцитов по объему (RDW). В сочетании с анамнезом пациентов эти тесты могут позволить исключить некоторые другие потенциальные причины микроцитарной анемии21.
Диагноз трансфузионно-независимой талассемии
| Промежуточная β‑талассемия | HbЕ / β‑талассемия | Болезнь HbН | |
|---|---|---|---|
| Уровни Hb | 7-10 г/дл20 |
|
|
| Анализ ДНК | В случае патологических результатов общего клинического анализа крови проводится генетический анализ для идентификации мутации20 | Для дифференциальной диагностики другими формами малой талассемии24 | Для 7 типичных для α-талассемии делеций разработана Gap‑PCR25 |
| ВЭЖХ Электрофорез |
|
|
|
| Мазок крови |
|
|
|
Варианты лечения
Варианты лечения талассемии включают потенциально радикальные и поддерживающие методы терапии28.
- Трансплантация гемопоэтических стволовых клеток
- Гемотрансфузии
- Спленэктомия
- Гормонозаместительная терапия
- Терапия хелаторами железа
Трансплантация гемопоэтических стволовых клеток
Трансплантация гемопоэтических стволовых клеток является единственным потенциально способным привести к излечению подходом к терапии талассемии. Возможность использования этого варианта терапии ограничена сложностью подбора подходящего донора. Хотя в некоторых случаях были достигнуты прекрасные результаты, у пациентов с поражением печени, обусловленным перегрузкой железа, результаты терапии не столь благоприятны28.
Гемотрансфузии
Частые гемотрансфузии играют ключевую роль для жизни пациентов с большой β-талассемией. Несмотря на достигнутые улучшения в области поддерживающей терапии по поводу β-талассемии (см. Рисунок 7), включая гемотрансфузии, эти виды лечения могут сопровождаться развитием осложнений. Перегрузка железом является одним из основных осложнений у пациентов, получающих гемотрансфузии. У больных, получающих большой объем трансфузий, основной причиной смерти являются заболевания сердца, возникающие в результате связанной с трансфузиями перегрузки железом.

Рисунок 7. Достижения в области терапии β-талассемия29
У пациентов с трансфузионно-независимой талассемией на ранних стадиях заболевания гемотрансфузий, как правило, удается избежать, их сохраняют в качестве резерва для применения в случае развития осложнений. По результатам недавних исследований у пациентов, которые получали регулярные или периодические гемотрансфузии, наблюдалось меньшее количество осложнений, обусловленных хронической анемией, неэффективным эритропоэзом и гемолизом, включая легочную гипертензию и тромбозы. Тем не менее, у пациентов, которым проводились гемотрансфузии, наблюдалась более высокая частота осложнений, обусловленных перегрузкой железом. Таким образом, гемотрансфузионная терапия в случае ее проведения требует тщательного мониторинга, и ее необходимо тщательно подбирать под потребности конкретного пациента10.
Продолжается совершенствование руководств по трансфузионной терапии у пациентов с трансфузионно-независимой талассемией. Показания к гемотрансфузиям включают26.
- Уровень Hb <5 г/дл
Состояния с предполагаемым острым стрессом, снижением гемоглобина или кровопотерей, например:
- Беременность
- Хирургические вмешательства
- Инфекции
- Снижение уровня Hb в сочетании с выраженным увеличением селезенки
- Задержка роста
- Костные изменения
- Частые гемолитические кризы
- Низкое качество жизни
- Лечение, первичная или вторичная профилактика осложнений, например, тромбозов, заболеваний сердца и язв ног
Спленэктомия
Согласно имеющимся сведениям хирургическое удаление селезенки повышает уровень Hb на 1-2 г/дл, и у некоторых пациентов наблюдается значительное улучшение роста и развития. Тем не менее, у пациентов после спленэктомии наблюдается более высокая частота тромбозов. Кроме того, инфекции у пациентов после спленэктомии характеризуются высокой смертностью (в особенности у детей с заболеваниями крови). Таким образом, спленэктомию следует проводить только в случае крайней необходимости10.
Спленэктомия может быть показана пациентам с ежегодной потребностью в эритроцитах выше 180-200 мл/кг18.
Прочие показания к спленэктомии включают10.
- Симптомы увеличения селезенки с лейкопенией или тромбоцитопенией, вызывающей клинические проблемы, например, рецидивирующие бактериальные инфекции или кровотечения.
- Спленомегалия с такими симптомами, как боль в верхнем квадранте живота или раннее чувство насыщения (что связано с возможным разрывом селезенки).
Лейкопения
Патологическое снижение количества лейкоцитов6.
Тромбоцитопения
Патологическое снижение количества тромбоцитов6.
Гипогонадизм
Ненадлежащая секреция половых гормонов6.
Парентеральный
Обозначает любые способы применения препаратов кроме перорального приема, например, внутривенные, подкожные, внутримышечные введения или нанесение на слизистые оболочки6.
Гормонозаместительная терапия
Нарушение роста и развитие эндокринных заболеваний, в частности, гипогонадизма, - это типичные осложнения талассемии. Данные клинические проявления вызываются как хронической анемией, так и перегрузкой железом, при этом чаще они развиваются у пациентов более старшего возраста28.
Пациентам с дефицитом гормона роста, задержкой полового созревания или нарушением фертильности, а также с дисфункцией щитовидной железы может быть показана надлежащая гормонозаместительная терапия18,28.
Терапия хелаторами железа
Хелаторная терапия с использованием хелатирующих препаратов, которые образуют комплекс с железом и стимулируют его экскрецию. Данная форма терапии может вывести несвязанное с трансферрином железо, удалить избыток железа из клеток и поддерживать или восстановить безопасный уровень железа30.
У пациентов без трансфузий перегрузка железом развивается более медленно по сравнению с пациентами, получающими регулярные гемотрансфузии. В любом случае может осуществляться мониторинг перегрузки железом и ее потенциальный контроль при помощи хелаторов железа10.
В отличие от пациентов с большой β-талассемией, у которых анамнез гемотрансфузий может использоваться в качестве индикатора для определения времени начала хелаторной терапии, пациентам с трансфузионно-независимой талассемией необходим непосредственный анализ уровня железа в организме. У этих больных следует оценить содержание железа в печени (LIC) при помощи биопсии или (более предпочтительно) неинвазивных методов визуализации (например, МРТ печени; это необходимо делать каждые 1-2 года)10.
Наиболее значимые аспекты: Исследование THALASSA
Хелаторная терапия является единственным вариантом, доступным для снижения уровня железа в организме у пациентов с трансфузионно-независимой талассемией. Клиническое исследование THALASSA представляет собой первое рандомизированное плацебо-контролируемое исследование по оценке хелаторной терапии у пациентов с трансфузионно-независимой талассемией. Деферазирокс (изучаемый в этом исследовании препарат) – это хелатор железа для перорального приема 1 раз в сутки с подтвержденным профилем эффективности и безопасности у пациентов с анемиями, требующими хронических гемотрансфузий. В этом исследовании деферазирокс статистически значимо снижал перегрузку железом у пациентов с трансфузионно-независимой талассемией по сравнению с плацебо, при этом общая частота нежелательных явлений была схожа12.
Основная задача хелаторной терапии у пациентов с талассемиями заключается в постоянном поддержании безопасных уровней железа. У пациентов с талассемиями оценивали применение парентерального хелатора железа дефероксамина и пероральных хелаторов железа – деферипрона и деферазирокса. По результатам клинической оценки наблюдалось улучшение уровня ферритина сыворотки, концентрации железа в печени, уровня железа в сердце и выживаемости34,35.
Список литературы
- Benz EJ. Disorders of Hemoglobin. In: Longo DL, Kasper DL, Jameson JL, et al, eds. Harrison's Principles of Internal Medicine. 18th ed. New York, NY: McGraw-Hill Companies, Inc.; 2012:852-861.
- Giardina PJ, Steiberg MH. Thalassemia Syndromes. In: Hoffman R, Benz EJ, Shattil SJ, et al, eds. Hematology: Basic Principles and Practice. 5th ed. Philadelphia, PA: Elsevier; 2009:535-563.
- Tortora GJ, Derrickson B. The cardiovascular system: the blood. In: Roesch B, Berry M, Muriello L, et al, eds. Principles of Anatomy & Physiology. 13th ed. Hoboken, NJ: John Wiley & Sons, Inc.; 2012:728-756.
- Cappellini MD. The Thalassemias. In: Goldman L, Schafer AI, eds. Cecil Medicine. 24th ed. Philadelphia, PA: Elsevier; 2012:1060-1066.
- Kumar V, Abbas AK, Fausto N, et al. Red blood cell and bleeding disorders. In: Kumar V, Abbas AK, Fausto N, et al, eds. Robbin and Cotran Pathologic.
- Venes D, Biderman A, Fenton B, et al, eds. Taber's Cyclopedic Medical Dictionary. 21st ed. Philadelphia, PA: F.A. Davis Company; 2009.
- Thalassaemia International Foundation. Guidelines for the Clinical Management of Thalassaemia. 2nd revised edition. 2008. Available at: httр://thаlаssaemia.org.cy/publications.html. Accessed February 14, 2012.
- Shawky RM, Kamal TM. Thalassemia intermedia: An overview. The Egyptian Journal of Medical Human Genetics. 2012;13:245-255.
- Forget BG, Olivieri NF. Hemoglobin synthesis and the thalassemias. In: Handin RI, Lux SE, Stossel TP, eds. Blood: Principles and Practice of Hematology. 2nd ed. Philadelphia, PA: Lippincott Williams & Wilkins; 2003:1503-1596.
- Cotran RS, Kumar V, Collins T. Red cells and bleeding disorders. In: Robbins Pathologic Basis of Disease. 6th ed. Philadelphia, USA: W.B. Saunders Company; 1999:601-643.
- Taher AT, Musallam KM, Cappellini MD, et al. Optimal management of beta thalassaemia intermedia. Br J Haematol. 2011;152(5):512-523.
- Fucharoen S, Ketvichit P, Pootrakul P, et al. Clinical manifestation of beta-thalassemia/hemoglobin E disease. J Pediatr Hematol Oncol. 2000;22(6):552-557.
- Taher AT, Porter J, Viprakasit V, et al. Deferasirox reduces iron overload significantly in nontransfusion-dependent thalassemia: 1-year results from a prospective, randomized, double-blind, placebo-controlled study. Blood. 2012;120(5):970-977.
- HiggsDR, EngelJD, StamatoyannopoulosG. Thalassaemia. Lancet. 2012;379(9813):373-383. Taher AT, Cappellini MD, Musallam KM. Recent advances and treatment challenges in patients with non-transfusion-dependent thalassemia. Blood Rev. 2012;26 Suppl 1:S1-S2.
- Benz EJ. Disorders of hemoglobin. In: Longo DL, Kasper DL, Jameson JL, et al, eds. Harrison's Principles of Internal Medicine. 18th ed. New York, NY: McGraw-Hill Companies, Inc.; 2012:852-861.
- Weatherall DJ. The definition and epidemiology of non-transfusion-dependent thalassemia. Blood Rev. 2012;26 Suppl 1:S3-S6.
- Musallam KM, Cappellini MD, Wood JC, et al. Iron overload in non-transfusion-dependent thalassemia: a clinical perspective. Blood Rev. 2012;26 Suppl 1:S16-S19.
- Galanello R, Origa R. Beta-thalassemia. Orphanet J Rare Dis. 2010;5:11.
- Hoffbrand AV, Taher A, Cappellini MD. How I treat transfusional iron overload. Blood. 2012;120(18):3657-3669.
- Galanello R, Origa R. Beta-thalassemia. Orphanet J Rare Dis. 2010;5:11.
- Muncie HL, Jr., Campbell J. Alpha and beta thalassemia. Am Fam Physician. 2009;80(4):339-344.
- Shander A, Berth U, Betta J, et al. Iron overload and toxicity: implications for anesthesiologists. J Clin Anesth. 2012;24(5):419-425.
- Fucharoen S, Viprakasit V. Hb H disease: clinical course and disease modifiers. Hematology Am Soc Hematol Educ Program. 2009:26-34.
- Vichinsky E. Hemoglobin e syndromes. Hematology Am Soc Hematol Educ Program. 2007;2007:79-83.
- Harteveld CL, Higgs DR. Alpha-thalassaemia. Orphanet J Rare Dis. 2010;5:13.
- Taher A, Vichinsky E, Musallam K et al. Guidelines for the Management of Non Transfusion Dependent Thalassemia (NTDT). Nicosia, Cyprus: Thalassaemia International Federation; 2013.
- Benz EJ. Disorders of hemoglobin. In: Fauci AS, Braunwald E, Kasper DL, et al, eds. Harrison's Principles of Internal Medicine. 17th ed. New York, USA: McGraw-Hill Medical; 2008:635-643.
- Rund D, Rachmilewitz E. Beta-thalassemia. N Engl J Med. 2005;353(11):1135-1146.
- Modell B, Khan M, Darlison M, et al. Improved survival of thalassaemia major in the UK and relation to T2* cardiovascular magnetic resonance. J Cardiovasc Magn Reson. 2008;10:42.
- Basis of Disease. 8th ed. Philadelphia,PA: Saunders Elsevier; 2010:639-675.
11280050/JAD/WEB/10.24/0